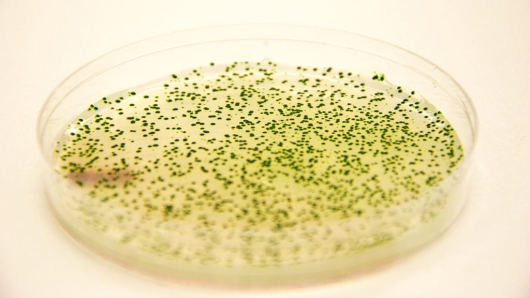
Genetically engineered strains of the cyanobacterium Synechococcus elongatus in a Petri di...

Bacteria engineered to convert greenhouse gas into liquid fuel
By Darren Quick
20:38 December 14, 2009 PST
As part of the push to reduce greenhouse gas emissions produced by burning fossil fuels researchers from the UCLA Henry Samueli School of Engineering and Applied Science have developed a greener way to extract biofuel from bacteria. The team has genetically modified a cyanobacterium to consume carbon dioxide and produce the liquid fuel isobutanol, which holds great potential as a gasoline alternative. As an added bonus that reaction is powered directly by energy from sunlight, through photosynthesis.
The method boasts dual benefits. Firstly it reduces greenhouse gas emissions resulting from the burning of fossil fuels by recycling CO2. And secondly it uses solar energy to convert the CO2 into a liquid fuel that can be used in the existing energy infrastructure, including in most cars.
While other alternatives to gasoline include deriving biofuels from plants or from algae, both of these processes require several intermediate steps before refinement into usable fuels. The research team says this new approach is potentially much more efficient and less expensive than the current approach as it avoids the need for biomass deconstruction, which is a major economic barrier for biofuel production.
Using the cyanobacterium Synechoccus elongatus, researchers first genetically increased the quantity of the carbon dioxide–fixing enzyme RuBisCO. Then they spliced genes from other microorganisms to engineer a strain that intakes carbon dioxide and sunlight and produces isobutyraldehyde gas. The low boiling point and high vapor pressure of the gas allows it to easily be stripped from the system.
Although the engineered bacteria can produce isobutanol directly, the researchers say it is currently easier to use an existing and relatively inexpensive chemical catalysis process to convert isobutyraldehyde gas to isobutanol, as well as other useful petroleum-based products.
The researchers say that placing the new system next to existing fossil fuel burning power plants would be ideal as it would potentially allow the greenhouse gases emitted from the power plants to be captured and directly recycled into liquid fuel.
Lead researcher James C. Liao, Chancellor's Professor of Chemical and Biomolecular Engineering at UCLA and associate director of the UCLA–Department of Energy Institute for Genomics and Proteomics, says, “We are continuing to improve the rate and yield of the production. Other obstacles include the efficiency of light distribution and reduction of bioreactor cost. We are working on solutions to these problems."
The UCLA team’s research appears in the Dec. 9 print edition of the journal Nature Biotechnology.
copyright © gizmag 2003 - 2009 To subscribe or visit go to: http://www.gizmag.com